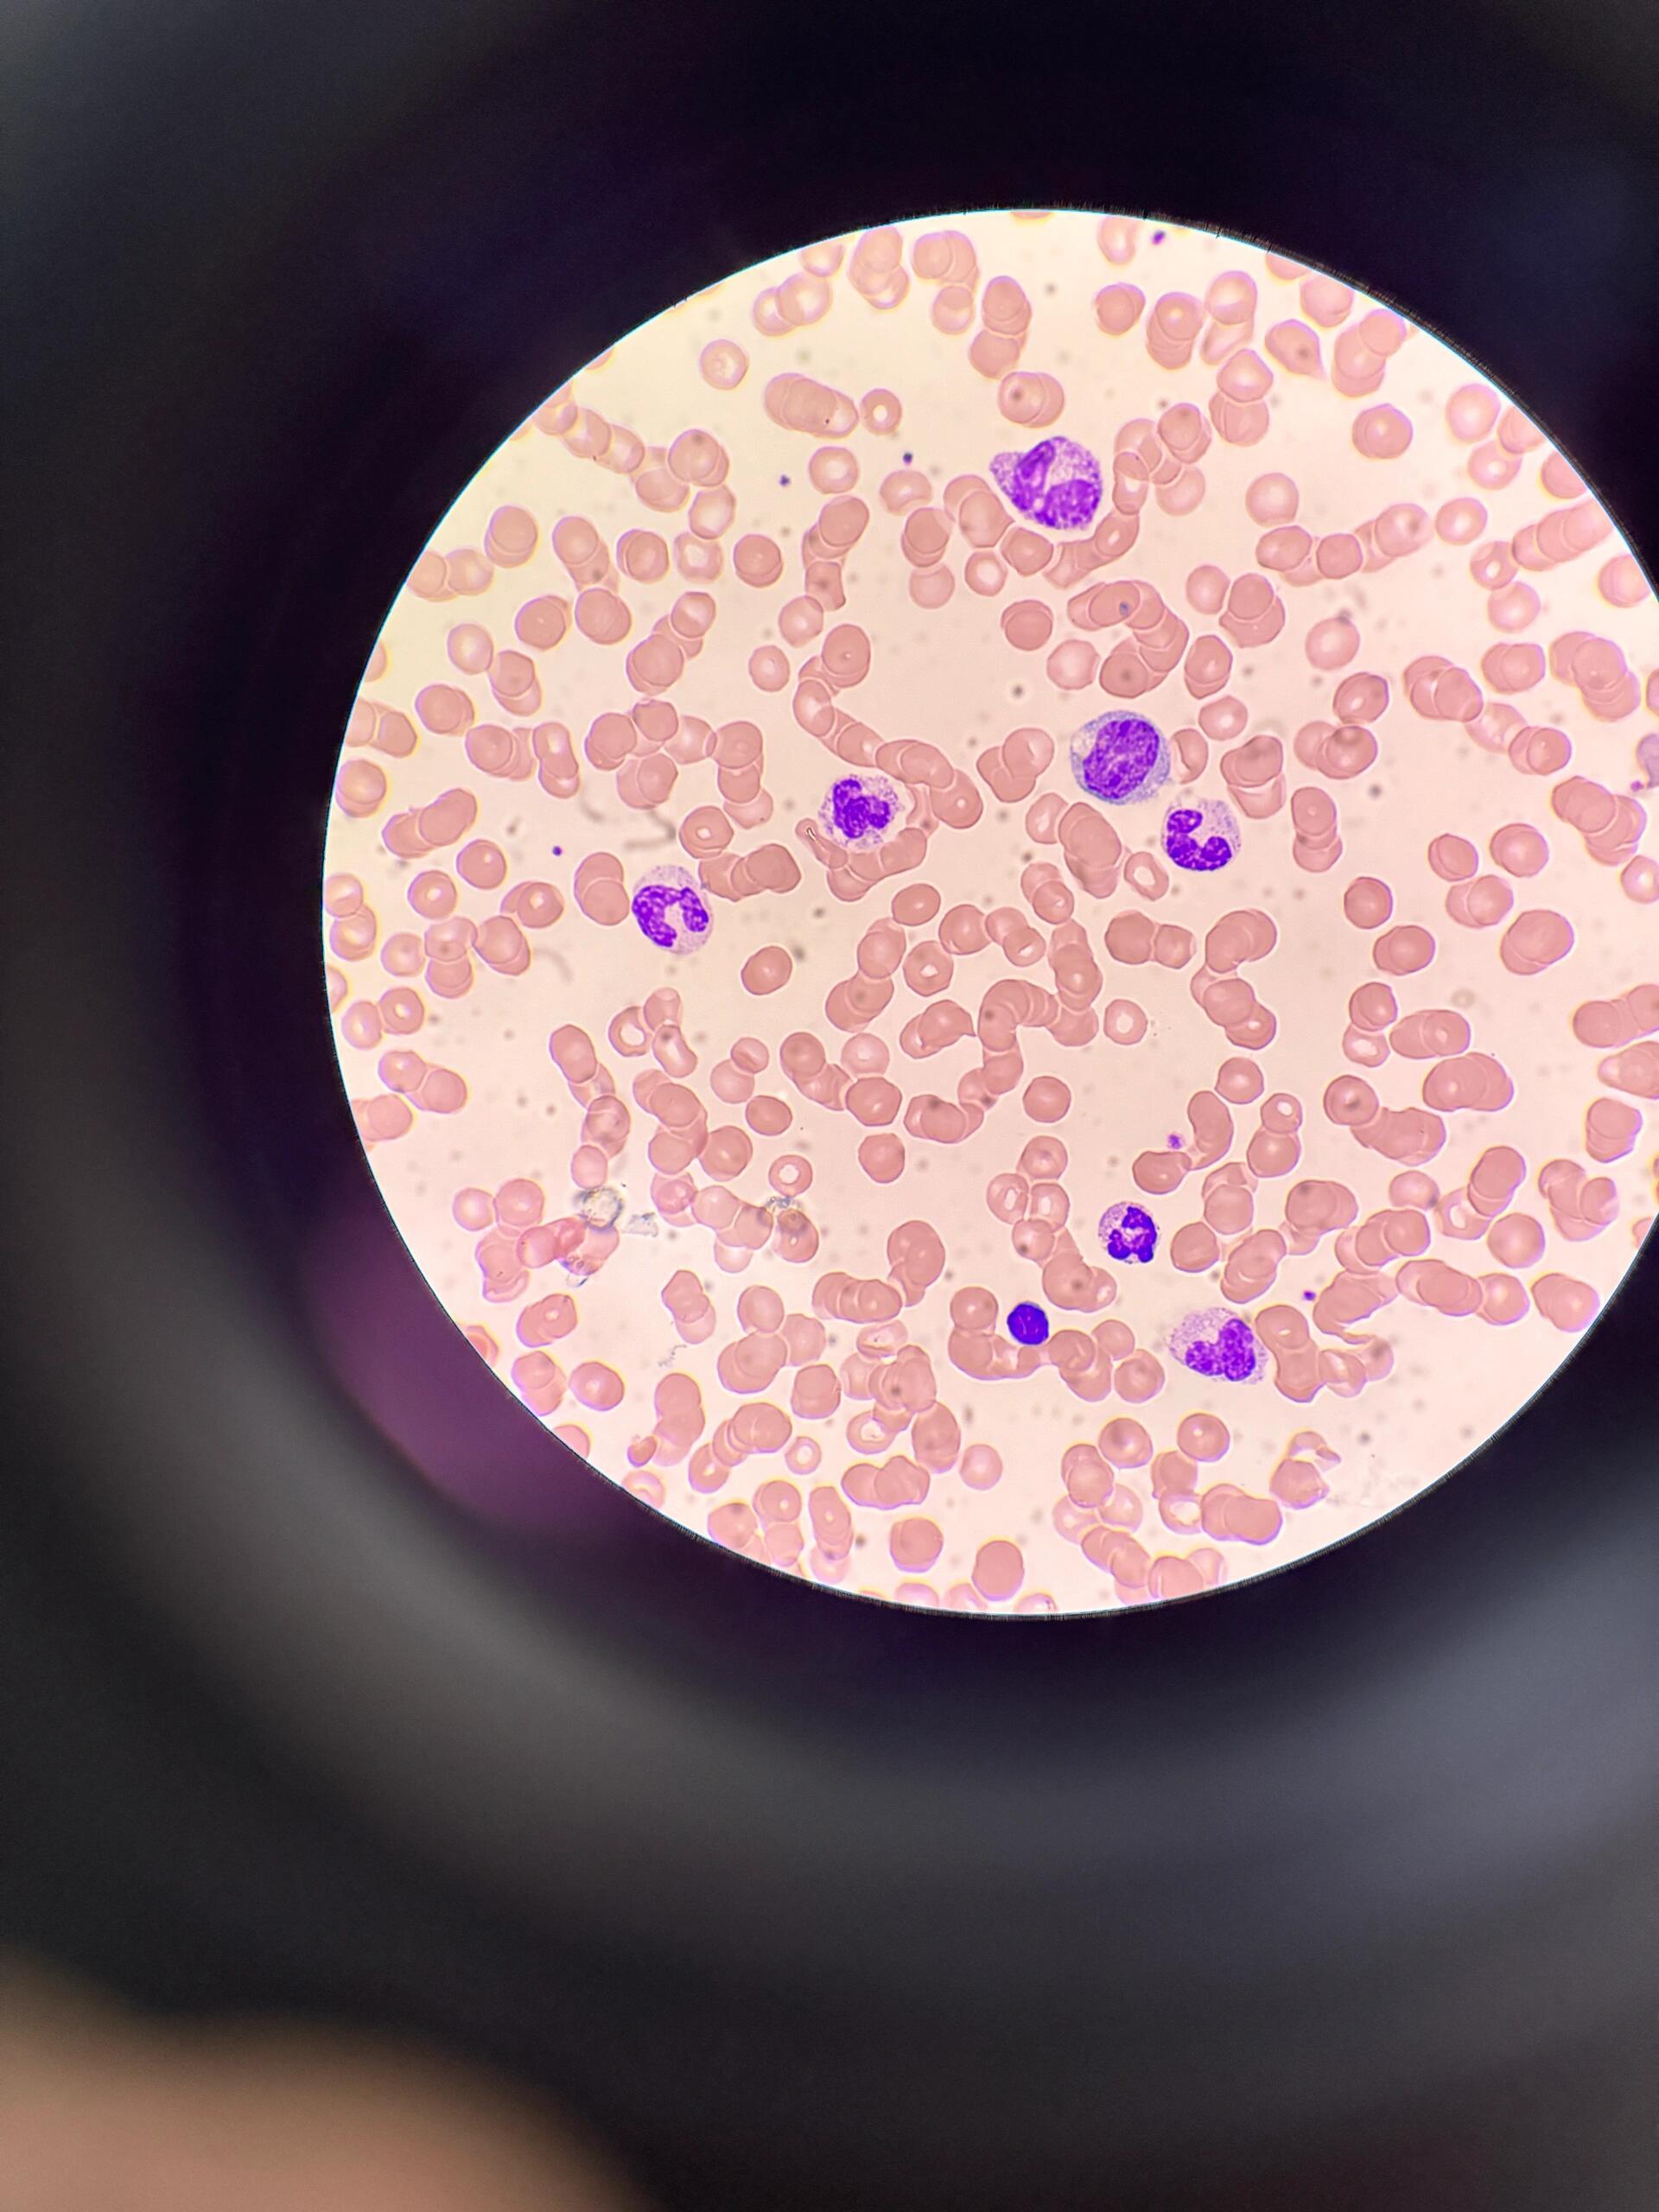
中性粒细胞百分比偏低

冬天嘴唇干裂脱皮原因有哪些
1、嘴唇长期干裂脱皮主要由气候不良生活习惯营养缺乏疾病及其他因素导致,具体如下气候因素干燥寒冷环境会加速嘴唇水分蒸发,尤其在冬季北方地区,风大湿度低,唇部皮肤薄且缺乏皮下脂肪保护,更易干裂脱皮炎热多汗环境中,大量出汗...
心力衰竭的临床表现是什么
一按临床表现分类 1根据病程和症状稳定性急性心力衰竭症状在短时间内突然加重,表现为突发严重呼吸困难端坐呼吸咳粉红色泡沫痰等,常由心肌梗死严重心律失常或急性瓣膜功能不全等诱因引发慢性心力衰竭症状呈长期性渐进性发展,表现...
中性粒细胞百分比偏低
中性粒细胞百分比偏低可能由感染药物自身免疫性疾病骨髓造血问题或其他因素引起,需通过进一步检查明确病因并针对性治疗具体分析如下感染因素某些细菌病毒或真菌感染可能导致中性粒细胞百分比偏低例如,流感普通感冒等病毒感染可能抑...
眼睛干涩是什么原因?
眼睛干涩的主要原因是角结膜干燥症,这是一种眼表疾病其发生机制通常与以下因素相关1老化因素随着年龄增长,眼表分泌泪液的腺体如泪腺睑板腺可能因生理性萎缩导致功能退化,泪液分泌量减少,无法形成稳定泪膜覆盖角膜表面2营养缺乏...
肾结核最主要的症状(肾结核的症状有哪些)
肾结核的病变过程非常缓慢,临床表现以膀胱刺激症状为主。因此对肾结核的诊断,是以膀胱炎的症状(尿频、尿急、尿痛)为线索。除有引起膀胱炎的明显原因外,都应考虑肾结核的可能,诊断必须作进一步的系统性检查。...
杏璞霜药膏在哪里能买到
面对过敏原抵抗力不足而引起的变态反应皮肤病因为荨麻疹,疗效慢的特殊性,建议其接受内调外治不建议使用西药或激素类药膏,此类药膏虽然疗效快,但是都治标不治本,会成耐药性,一直反反复复,以后会更加难以根治可以去中医院开些祛...

京公网安备11000000000001号
京公网安备11000000000001号 京ICP备11000001号
京ICP备11000001号